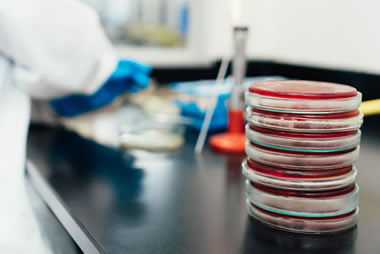

Legionella Testing Methods Compared
Legionella testing plays a valuable role in understanding and controlling the risk of bacteria within man-made water systems. While not always a legal requirement, testing provides a practical way to verify that control measures are working effectively and that conditions remain unfavourable for bacterial growth. From traditional laboratory-based methods to newer rapid and on-site technologies, there are now several options available, each offering different advantages in terms of speed, sensitivity and application.
This article explores the main Legionella testing technologies in use today, including culture testing, PCR analysis, rapid lateral flow kits and electrochemical luminescence techniques. It also highlights rapidly emerging technologies such as remote temperature monitoring and AI driven predictive analysis, alongside guidance on when testing may be required and how results should inform ongoing risk management. Together, these insights are intended to help both duty holders and the responsible person select the most appropriate approach for maintaining safe water systems.
A version of this article highlighting the different Legionella testing technologies currently available first appeared in Legionella Control International’s newsletter. To get it in your inbox, sign up here.
Legionella testing technologies
If you own, manage, or run a building that requires a Legionella risk assessment, you may also need to conduct Legionella testing to determine the current levels of bacteria in the water system. While not all situations require testing by law, it can be an excellent tool to use, especially where there is greater complexity involved in the water system or where you want to check the precautions you’ve implemented are effective.
This guide covers the key Legionella testing technologies available today. If you are looking at performing tests in your building, one or more of the following may be ideal for your purposes.
Legionella testing using the culture method
The culture method is performed in a laboratory and is the traditional way to test for Legionella bacteria. However, it also takes the longest to receive a result, taking approximately a week to 10 days to grow bacteria taken from water samples.

Laboratory analysis based on culture methods
Polymerase chain reaction (PCR) testing
The PCR method offers a more sensitive test compared to other “rapid test” options including the lateral flow option, see below. It does, however, take longer to get a result. Once you have the water sample and perform the test, you can typically receive a result within about 24 to 48 hours.
One downside of the PCR test is that it gives a result based on all Legionella bacteria present in the sample, regardless of whether they are alive or dead. This means you may get a result that suggests levels of live bacteria are higher than they are at that moment. However, if you get a concerning result, you can always follow up with a more detailed test of a different kind.
Rapid lateral flow test kits (LegionellaFAST)
These are an excellent tool to have on hand to assist you in maintaining a safe hot and cold water system. You can follow the instructions, take a sample and test it, and have results within about 25 to 35 minutes, depending on the kit you use… LegionellaFAST
The simplicity of the test means that anyone can follow the step-by-step instructions to get a result. While they are quite basic, they act as a good first step to take to determine whether additional testing should be done.
Electrochemical luminescence (ECL) technology
This is a more advanced technique that introduces a voltage that causes bacteria to emit light. In a basic sense, the more light that is emitted, the higher the concentration of Legionella bacteria present in the sample.
It can take an hour or two to receive the results from this type of Legionella testing. It can also be done on site without using a laboratory. Research shows that ECL technology can also provide detailed results, identifying even low levels of Legionella bacteria present in a water sample.
Other useful Legionella testing technologies to be aware of
Legionella most readily grows in water temperatures of between 20-45 degrees Celsius. Cold water should remain lower than 20 degrees, while hot water should be stored at above 50 degrees (55oC in healthcare).
Remote temperature monitoring
With advances in Internet connectivity, sensor and battery technologies you can now cost-effectively add remote temperature sensing technology to water systems that will alert you to any temperatures that fall into the danger zone for the growth of Legionella bacteria. While this isn’t a requirement, and would likely be best used in larger, complex or geographically remote systems, it is a good example of how technology can save money and assist in monitoring Legionella bacteria.
Predictive analysis
AI technology is also beginning to make a big difference. Researchers are looking at predictive analysis as a method for identifying situations that could lead to bacterial growth before it occurs.

Remote water temperature monitoring sensor
Are you required by law to test for Legionella bacteria?
You won’t be required to test for Legionella bacteria in many scenarios, but there are cases where this is a requirement. Notably, you must test quarterly if you manage and maintain one or more cooling towers, for example. Other examples include:
- Where you suspect the Legionella controls in place are ineffective
- Where hot and cold water temperatures are not being maintained
- Where there’s doubt over concentrations of disinfectant in the system that could indicate a lack of control
- Where the situation is deemed high-risk for some other reason
While you may not be required to take water samples for Legionella testing, there are many advantages in doing so. For example, test results provide a clear idea of whether you are doing enough to manage the risk of Legionella in your water system.
Good water safety practices begin with a Legionella risk assessment to identify all potential risks that could lead to a higher chance of Legionella bacteria being present. While you can often remove some risk factors, you may only be able to reduce others.
You would then set up a maintenance and cleaning routine and other control measures to ensure the Legionella bacteria do not rise above normal levels. Regular Legionella testing at different outlets within the system provides you with a way to check and confirm your measures are working as they should be.
Which Legionella testing methods are best in your situation?
Many people responsible for managing Legionella safety will use rapid on-site test kits as a first line of defence. In most cases, you won’t be required to test at all, unless specific circumstances are present, such as the presence of a cooling tower.
However, rapid test kits provide a good level of accuracy and can be a useful tool in your risk management efforts to make sure Legionella bacteria remains at a safe level. However, your approach should always begin with a Legionella risk assessment, which will identify risk factors for the bacterium. Once you have dealt with those, you will still need to maintain safe water temperatures, flush outlets where necessary, and clean and disinfect the system using an approved biocide. Legionella testing will help you confirm that your efforts in these areas are getting the desired results.
According to current technical guidance from the Health & Safety Executive, HSG274 part 2, the control of Legionella in hot and cold water systems, if levels of Legionella greater than 1,000 cfu/l (colony forming units per litre) are detected, you should take another sample and review your risk assessment. You should also review the current measures you are using to control Legionella. You may need to disinfect the entire water system and monitor more closely until the situation is confirmed to be under control. In this situation, a more accurate test requiring laboratory cultures would be highly recommended to gain the most in-depth and accurate information.

Water safety group meeting to discuss Legionella water sampling strategy
Improving long-term water safety using Legionella testing
In practice, there is no single “best” Legionella testing method that suits every system. As outlined above, each technology offers its own balance of speed, accuracy and practicality, making it important to align your choice with the level of risk, the complexity of your water system and the outcomes you need. In many cases, a combination of approaches … such as routine rapid testing supported by periodic laboratory analysis can provide a more complete picture and greater confidence that control measures remain effective.
Ultimately, Legionella testing should be viewed as part of a wider, proactive water safety strategy rather than a stand-alone solution. When used alongside a thorough Legionella risk assessment, consistent temperature control and regular maintenance, it becomes a powerful tool for verifying that your water systems are operating safely. By understanding the strengths of the different testing technologies available, you can take a more informed and measured approach to managing Legionella risk over the long term.
Expert support fro the UK’s leading water safety specialists
Understanding the range of Legionella testing technologies available is only one part of maintaining a safe and compliant water system. Interpreting results correctly, selecting the most appropriate testing approach and ensuring that findings translate into effective control measures all require experience and a clear, structured strategy. This is where specialist support can make a significant difference, particularly in higher-risk or more complex environments.
Leading water safety specialists Legionella Control International provide expert guidance to those responsible for managing Legionella and other waterborne pathogens across a wide range of settings, including healthcare, commercial and industrial properties. Our experienced teams support organisations with Legionella risk assessments, water safety auditing, training and ongoing consultancy, helping to ensure systems remain safe, compliant and effectively managed. We also bring extensive experience in Authorising Engineer (Water) roles, assisting in the development of robust water safety management frameworks for large or multi-site operations.
If you would like further advice on Legionella testing, or support in reviewing your current water safety arrangements, our specialists are here to help. Get in touch today on 0330 223 36 86 to discuss your requirements and ensure your water systems are being managed with confidence.

